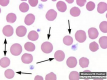

Otros juegos similares:
Otros juegos similares:
Otros juegos similares: